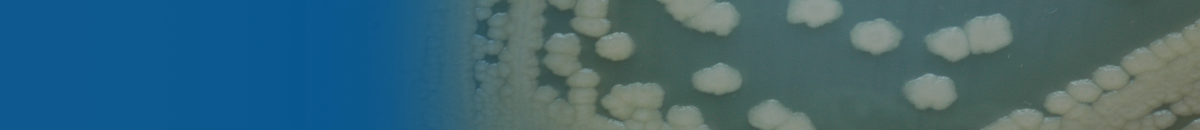

|
Národní program konzervace a využívání genetických zdrojů mikroorganismů a drobných živočichů hospodářského významu |
česká verze english version kontakt |
Vyhledávání v databázi 32 sbírek mikroorganismů a bezobratlých - účastníků Národního programu.
Procedura objednávání a distribuce genetických zdrojů:
Kmeny jsou distribuovány na základě písemné objednávky doručené konvenční poštou, elektronicky či osobně.
Sbírky se při administrativním vyřizování objednávek řídí příslušnými legislativními požadavky.
Jak získat kmen:
Kmen se nedá objednat centrálně. U příslušného kmenu je vždy uvedena sbírka (odkaz - název sbírky), ve které je kmen uložen.
Na stránkách sbírky je uveden kontakt na kurátora, u kterého je možné kmen získat.